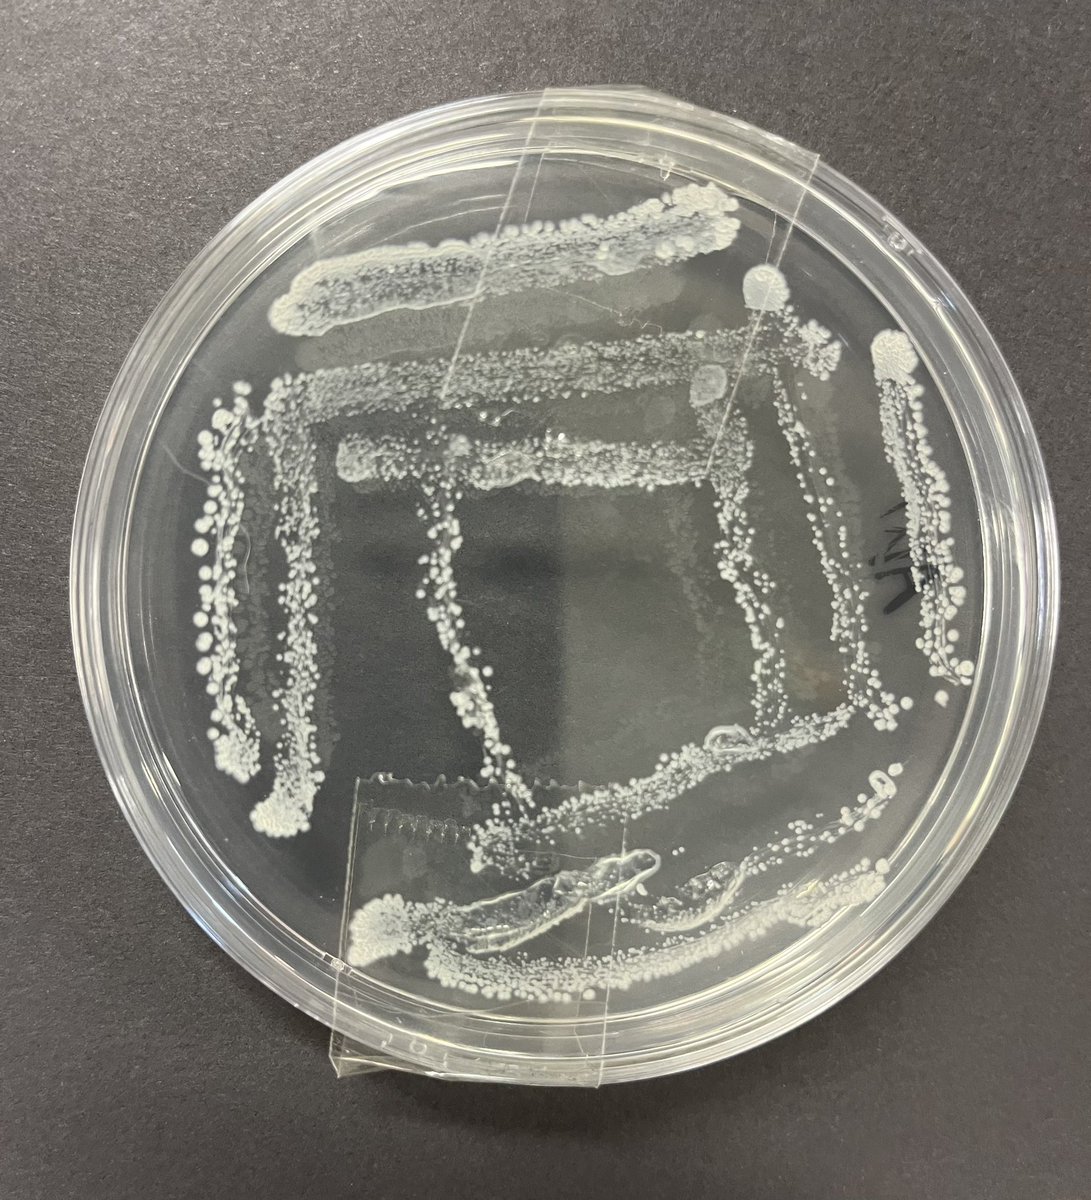
bhs_biodept's tweet image. Year 10 biologists have been learning how to carry out aseptic technique effectively to transfer a bacterial culture to an agar plate. This streak plate showed no contamination so well done to Abigail for her exemplary technique!

BHS Biology
@bhs_biodept
Biology @ Ballyclare High School. Interesting information relevant especially for GCSE and A Level students
You might like
Another super morning with our STEM Ambassadors visiting P5 at @BallynurePS to investigate and build parachutes that will safely deliver an astronaut onto Mars. What a super bunch of scientists they were! @BallyclareHigh @STEMHubNI

What a brilliant day we had today with some of our Year 9 scientists taking part in the #IETFaradayChallengeDay with our friends at @W5Education Congratulations to 9R on their winning design! @BallyclareHigh @IETeducation

Our Year 13 biologists had a fantastic day at @DiscoverCAFRE Greenmount Campus putting their environmental biology theory into practice. Lots of opportunity to see the various agricultural practices at work aswell as carrying out some sampling techniques




We’ve loved taking part in the RSPB Big Schools Birdwatch again this year - we were surprised to spot so many gulls in our grounds though! @Natures_Voice @RSPBNI




What a great end to the week with Yr 13 doing some edible revision of the ultrastructure of cells




Out on the road again! We were delighted to have some STEM ambassadors visit @BallynurePS this morning to deliver a christmas science workshop. Another very impressive group of young scientists in P3 and P4! @STEMHubNI @BallyclareHigh

It was wonderful to have some of our STEM Ambassadors visit @KilbrideCPS today to deliver a Christmas STEM workshop to P6. What a fantastic group of young scientists they were! @BallyclareHigh @STEMHubNI



A great end to #BiologyWeek with our Great Biology Bakeoff event. So much creativity displayed! Congratulations to all our winners and thanks to our STEM ambassadors for organising the event @RoyalSocBio




We were delighted to have Anna from @STEMHubNI back in school today to complete the STEM Ambassador registration for some of our Year 13+14 Young Ambassadors. What a group they are! 🎉🧬🔭

Thanks to @RSBWestMids for organising this lecture from Professor Frigerio @uniofwarwick for #BiologyWeek . Fascinating to learn more about the current research into the ER and vacuoles of plant cells for our A level students and staff

#BiologyWeek going well so far with the BioHunt providing lots of lunchtime fun for our junior pupils as they search our school for the answers to the clues they have been given. Lots more to come this week @RoyalSocBio @RSB_NI_branch


Thanks to @KJF239 for sharing these resources to model the tricky A level topic of Action Potentials- we found it so helpful!

Some excellent results from our Year 11 biologists investigating if chlorophyll is needed for photosynthesis by carrying out a starch test on a variegated leaf ☘️

For any budding photographers- enter your photos into this competition by 31st October
Get another look at last year's #InsectWeek #Photography #Competition 📸 Have you entered the #InsectWeek23 photography and art competitions yet? Enter now: insectweek.org/art-and-photog… #WildlifePhotography #MacroPhotography #NaturePhotography #Insects #InsectPhotography #Macro

Year 10 biologists have been learning how to carry out aseptic technique effectively to transfer a bacterial culture to an agar plate. This streak plate showed no contamination so well done to Abigail for her exemplary technique!
What a joy to celebrate with Fern (Yr14) tonight in the Long Gallery at Stormont as she presented her Nuffield Research Project on nature-based coastal defences and received her certificate. Definitely a summer well spent 👏 thanks @STEMHubNI @STEMLearningUK @BallyclareHigh

We are delighted to introduce our new cohort of Year 13 STEM Ambassadors who will join the Year 14 team in supporting and delivering STEM activities in both @BallyclareHigh and our partner primary schools. We are excited for the year ahead! @STEMHubNI

Another fantastic opportunity for some @BallyclareHigh students this summer 👏👏
Wow July where did you go? Well done to all the @NuffieldFound #research #experience students👏🥼🪐💁♂️🦺👩🔬Students have brought fresh thinking and new #ideas to the floor and have considered #university #apprenticeships going forward into Yr14 👏Good Luck and thankyou #hosts

We were delighted that some of our @BallyclareHigh pupils had the opportunity to attend this 👍🏻 we can’t wait to hear all about it!
Wow July where did you go? Well done to all the @NuffieldFound #research #experience students👏🥼🪐💁♂️🦺👩🔬Students have brought fresh thinking and new #ideas to the floor and have considered #university #apprenticeships going forward into Yr14 👏Good Luck and thankyou #hosts

We hope you are all enjoying the break so far- have a go at this citizen science experiment if you fancy an activity some day soon 🦋bbc.co.uk/news/uk-northe…
United States Trends
- 1. Venezuela 3,46 Mn posts
- 2. Venezuela 3,46 Mn posts
- 3. China 589 B posts
- 4. Congress 417 B posts
- 5. Nicolás Maduro 1,57 Mn posts
- 6. Cuba 259 B posts
- 7. Noriega 58,4 B posts
- 8. Taiwan 135 B posts
- 9. USS Iwo Jima 27,9 B posts
- 10. The US 1,19 Mn posts
- 11. Iraq 138 B posts
- 12. Panama 55,5 B posts
- 13. Caracas 1,43 Mn posts
- 14. Iran 1,78 Mn posts
- 15. #madurocaptured 10,5 B posts
- 16. Estados Unidos 1,02 Mn posts
- 17. Delta Force 110 B posts
- 18. Chavez 338 B posts
- 19. Monroe Doctrine 12,9 B posts
- 20. Libya 48,3 B posts
Something went wrong.
Something went wrong.











































































































